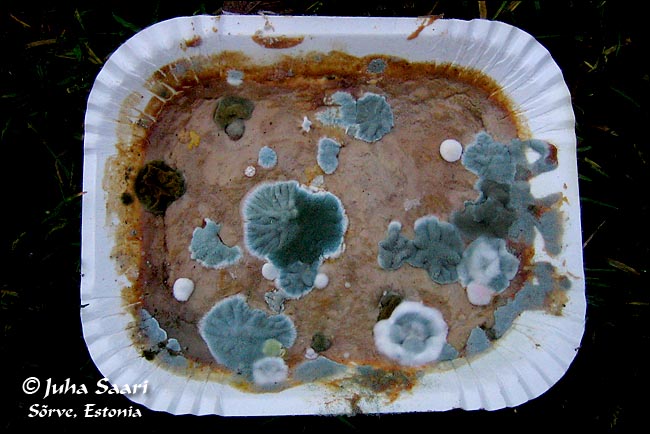
2006 11 28 2

Sõrve
Station Feed
Authentication Required
Gusse
December 5, 2006 14:00
Henkilöt: M.Martinson, J.Saari, H.Pietarinen, G.Nordenswan
Lajimäärä: 41
Sää: 8.00 +7, 15 SSW, 8/8, 10-20km
12.00 +8, 15 SSW, 7/8, 10-20km
jjuju
December 4, 2006 14:00
Meidän reissu lintulahdelle onnistuu yli odotusten ja kuittaan itse kuusi talvipinnaan. Gusselle ei vieläkään saada himottuja pinnoja. Mati on samaan aikaan kunnostautunut aseman kotilahdella ja nähnyt mm. jouhisorsan ja taivaanvuohen. HP on pysytellyt asemalla puuhastellen tarpeellisia kotitöitä. Saunakin on lämpiämässä. Illalla on taas hurjia tarinatuokioita maailman historista.
Henkilöt: J.Saari, G.Nordenswan, H.Pietarinen, M.Martinson
Lajimäärä: 24
Sää: 09:00 +6, S 11 m/s, 8/8, 4-10 km, vesisadetta
15:00 +7, SSW 12 m/s, 6/8, 10-20 km

2006 12 04 1
Gusse
December 3, 2006 14:00
Juju ilmoitti, että pitää lähteä Loodeen jatkamaan valtamerilintustajia. Hoopee totesi ravintolan kutsuvan, jos vaikka Heinmaa järjestäisi siellä rääppiäiset. Itse päätin pienen harkinnan jälkeen lähteä pitkälle polkupyöräretkelle. Sää selkleni lopuksi kokonaan ja reitti Kulki Maanteekylän kautta Montuun, missä pieni staji. Sitten poikkeama Kaaviin, Läätsän kautta Lou-lahteen, Kaunispeen, Jämajan hautausmaalle, iltahämärissä evästauko Laadlassa ja hienossa kuutamossa viimeiset 10 km asemalle, missä Hoopee ja Juju odotti lämmitetyssä saunassa.
Tämä oli tervetullutta, sillä kilometrejä oli siinä vaiheessa takana vajaa 90. Lintuja oli alussa hyvin niukasti, ainoana valopilkkuna Montun kohdalla koiras isokäpylintu, mistä päivän ensimmäinen talvi-prosu. Kaavi oli täysin kuollut, kuten Läätsäkin, mutta Lou-lahden suunnatomilla aakeiilla laakeilla alkoikin sitten löytymään lintuja, joskin pinta-alaan nähden edelleen niukasti.
Ensin näkyi hiirihaukka, sitten Hali ajoi lentoon 5 töyhtöhyyppää ja itse taivaanvuohen. Seuraava havainto oli 4 haapanaa, jota seurasi Viron 2:nen talvi-lapasorsa. Hetkeä myöhemmin jostain saapui hanhiparvi, jossa 3 lajia: 24 valkoposkea, 4 sepel- ja 1 tundrahanhi, kaikki talviprosuja. Siihen se tykitys sitten loppui, jollei huomioida Rahusteessa hemppoa ja Kaunispeessa Kulorastasta. Kovasta yrityksestä ja huippu-säästä huolimatta uusia talvipinnoja ei siis tullut.
Asema-alueella pojat olivat sillä aikaa löytäneet kokonaiset 57 lajia, parhaina talvilajeina mainittakoon merihanhi, rautiainen Loodessa, pulmunen, punarinta ja muuta semmoista. Mainittakoon, että mustarastas on edelleen havaitsematta koko Sörven suurniemeltä! Räksäkin on melkoinen rari, useimpina päivinä jää puuttumaan. Urpiainen on ainoa normaalia runsaampi laji. Melko erikoinen vuosi. Kaavissa tieltä löytyi aivan tuore yli-ajettu vaskitsa ja pähkinäpensas on paikoin alannut kukkimaan. Kevätmuuton vilkastumista odotellaan.
Henkilöt: J.Saari, G.Nordenswan, H.Pietarinen, M.Martinson
Lajimäärä: 57
Sää: 10:00 +7, WSW 10 m/s, 6/8, 10-20 km

2006 12 03 1
Gusse
December 2, 2006 14:00
Matkaväsymyksen takia pääsin liikkeelle vasta klo 9, eli oleellisin lintuaika oli jo menetetty tältä päivältä. Aamu oli yllättävän heikkotuulinen ja lupaavan oloinen. HP oli heti aamun valjetessa suunnannut ravintolan kulmaan, missä pitkästä aikaa näkyi elämää, piipusta tuprusi savua. Pian ilmeni että taloa oltiin lämmittämässä Heinmaan 50-vuotisbileitä varten.
Muutto käsitti lähinnä ruokkeja ja kalalokkeja, mutta liki kymmenen vuoden takaisista ennätysluvuista jäätiin hyvin kauas. Kun en keksinyt parempaa strategiaa päätin kompata rannan Mõntuun ja takaisin. Nykyään kun Suurerahun pitkän kaavan komppaus on mennyt mahdottomaksi mannerjäätiköiden suulaamisen myötä. Reilu 10 km lenkki sujui rauhallisesti, varsinkaan kun linnut eivät häirinneet etenemistä.
Ainoa merkittävämmin esiintyvä laji oli urpiainen, joiden joukosta poimin pari vanhaa turbo-koirasta, nuoria kun en tunne. Muita maalintuja löytyi koko 4h lenkillä vain 1 peippo, pari viherpeippoa, 3 isolepinkäistä ja muutama tali-, kuusi ja sinitiainen. Rastaita, sekä viime vuonna satamäärin esiintyneitä järrejä ei näkynyt ensimmäistäkään. Kaikenkaikkiaan on todettava, että ikinä aikaisemmin ei ole näin niukkaa ollut.
Paluumatkalla metsästä lähti sentään pari lehtokurpaa jaloista, mikä oikeasti oli päivän ainoa vähänkään vähälukuisempi talvilaji. Palaatessa HP tiesi kertoa että Heinmaa grillaa ravintolan pihassa kokonaista villisikaa barbecuena. Päätettiin lähettää tunnustelija selvittämään olisiko mahdollista liittyä juhliin. Paikan päällä meininki näytti kuitenkin varsin arvovaltaiselta ja ravintola sitäpaitsi täpötäydeltä. Autoja laskin parkissa yht. 28. Niinpä päätettiin antaa Heinmaiden jatkaa juhlintaa rauhassa ja mentiin kaikki kiltisti nukkumaan jo ennen klo 21.
Henkilöt: J.Saari, H.Pietarinen, G.Nordenswan, M.Martinson
Lajimäärä: 49
Sää: 10:00 +8, SW 6 m/s, 10-20km
14:00 +8, SSW 10 m/s, 2-4 km, tihkua

2006 12 01 1

2006 12 01 2
jjuju
December 1, 2006 14:00
Päivää jatkettiin metsiä kompaten, mutta sieltä on älyttömän vaikea löytää yhtään mitään. Täytyy vain ihmetellä, kuin toiset jaksavat löytää joka keikka jotain pikkukivaa. Lehtokurppiakin yritin tosissani, mutta vesiperä siitäkin tuli. Iltapäivällä lämmitettiin sauna ja valmisteltiin illallista. Seitsemän jälkeen haettiin Gusse Iiden bussiasemalta. Illalla spekuloitiin Gusselle uusia talvipinnoja.
Henkilöt: J.Saari, H.Pietarinen, M.Martinson
Lajimäärä: 45
Sää: 09:00 +7, SW 10 m/s, 7/8, 10-20 km
14:00 +9, WSW 11 m/s, 8/8, 10-20 km

2006 12 01 1

2006 12 01 2
jjuju
November 30, 2006 14:00
Huomenna alkaa siis talvi ja kaikki havainnot ovat merkityksellisempiä. Säästeltiin voimia ja siksi havikset jäivät vähäisiksi. Aamuinen hanhi sentään löytyy uudelleen, joutsenparvessa ruokaileva merihanhi. Olen kolunnut metsiä aika paljon, mutta jostain syystä esim. mustarastaat ovat täysin kateissa. Yhtään merulaa en ole tällä retkellä bongannut! HP pilkkoo iltapäivällä lämpimikseen halkoja.
Henkilöt: J.Saari, H.Pietarinen
Lajimäärä: 31
Sää: 09:00 +6, SW 8 m/s, 6/8, 10-20 km
14:00 +8, SW 9 m/s, 8/8, 10-20 km

2006 11 30 1

2006 11 30 2

2006 11 30 3
HP
November 29, 2006 14:00
Päivällä halonhaakkuuta ja saunanlämmitystä, iltapuolella aseman siivousta. Aloitettiin ns. olohuoneesta ja löydettiin melkein jätesäkillinen poltettavaa, käydään läpi muutkin huoneet lähipäivinä.
Henkilöt: J.Saari, H.Pietarinen, M.Martinson
Lajimäärä: 38
Sää: 10:00 +6, SW 7 m/s, 8/8, 1-2 km
13:00 +8, SW 6 m/s, 8/8, 500-1000 m

2006 11 29 1

2006 11 29 2

2006 11 29 3

2006-11-29 4
jjuju
November 28, 2006 14:00
Päivällä käytiin kaupassa kierrättämässä materiaa ja ostettiin jotain pientä tilalle. Satuin kaupan kassalle vanhemman <i>punanenäisen</i> miehen kanssa samaan aikaan. Mies oli juuri avaamassa olutpulloa ja yritin auttaa häntä toteamalla, että pullohan on Alcoholi vaba! Mies kuitenkin hymyili ja totesi, että niin pitääkin. Nolo juttu. Kaupan ulkopuolella kylän vakiojengi jatkoi oluen hörppimistään.
Iltapäivällä tein taas itärannan puskakomppauksen, mutta mitään ei löytynyt. Uskon kuitenkin, kun talvipinnakeisari Gusse saapuu, tilanne muuttuu paremmaksi. Suuri menetys asemalle oli J.Ojalan poistuminen paikalta, sillä jokainen silmäpari olisi tarpeen. Matin päivä lienee mennyt pääosin puutöissä, sillä jostain rannasta oli löytynyt kasa tukkeja. Asemanhoitajaa taidettiin kaipailla puiden siirtohommiin!
Henkilöt: J.Saari, H.Pietarinen, M.Martinsom
Lajimäärä: 53
Sää: 09:00 +7, SW 8 m/s, 8/8, 10-20 km

2006 11 28 1
2006 11 28 2
JO
November 27, 2006 14:00
Päivän kohokohta oli, saunan ja kaalisopan lisäksi, valkoposken iskenyt kanahaukka. Miltei samaan aikaan lensi muuttohaukka aivan lähietäisyydeltä yli. Olo oli kuin Disneyn luontodokumentissa. Jos olisi ajanut haukan pois saaliiltaan olisi saanut hanhipaistia. Keittokirja kuitenkin puuttui eikä reseptistä siten syntynyt yksimielisyyttä. Kun lopulta ajoimme haukan pois, se oli niin syövyksissä että tuskin pystyi lentämään.
Kovasti on pohjustettu Gussen talvipinnaprojektia mutta yhtään ei ole vielä löytynyt. Paitsi sinisorsa ja varis.
Henkilöt: M.Martinson, J.Ojala, J.Saari, H.Pietarinen
Lajimäärä: 50
Sää: 8.00 +8, 8/SW, 4/8, 10-20km
12.00 +9, 8/SW 2/8, 10-20km

2007 11 27 1
JO
November 26, 2006 14:00
Mati ripusteli metsästyksen kieltäviä tauluja pariin paikkaan. Toivottavasti tehoavat! Ohessa myös valokuva ystävällisestä komppauskaveristani. Sääli etteivät koirat osaa kirjata havaintojaan tietokantaan. Valkkarit eivät koiraa pelkää lainkaan eikä se liioin niitä jahtaa. Kysyin jokin aika sitten omistajalta koiran nimeä mutta olen sen jo unohtanut. Jotakin oolla alkavaa se oli. Aamulla kun sille sanoo tere, niin se tulee luokse ja häntää alkaa heilua. Olkoon siis Tere!
Henkilöt: M.Martinson, J.Ojala
Lajimäärä: 45
Sää: 8.00 +8, 6 SW, 8/8, 4-10 km
12.00 +9, 6 SW, 8/8, 4-10 km

2006-11-26 1

2006-11-26 2

2006-11-26 3

2006-11-26 4